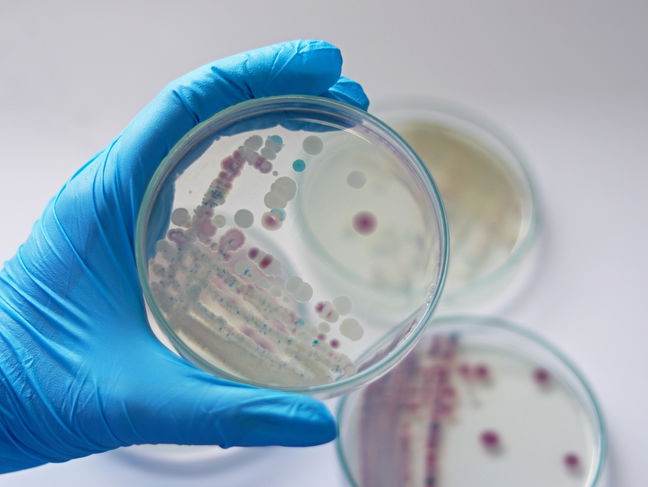
Investigador sosteniendo una placa de Petri

Vibrio vulnificus es un tipo de bacteria "come carne" que se encuentra en aguas costeras cálidas, la cual puede causar infecciones graves en las personas, especialmente después de comer mariscos crudos o cuando heridas abiertas entran en contacto con agua de mar.
Aunque las infecciones son poco comunes, Vibrio vulnificus puede provocar enfermedades graves o incluso la muerte en algunos casos. Esta bacteria se propaga con rapidez y puede causar síntomas como fiebre, vómito y lesiones en la piel. En situaciones graves, la infección puede dañar los tejidos y pasar al torrente sanguíneo.
Los casos de Vibrio vulnificus son más frecuentes durante los meses cálidos y en zonas donde aumentan las temperaturas del mar. Las personas con el sistema inmunitario debilitado o con enfermedades crónicas tienen un mayor riesgo de presentar complicaciones por esta infección.
Cómo ocurre la infección
Vibrio vulnificus puede entrar al cuerpo de dos formas principales:
- Al consumir mariscos crudos o poco cocidos contaminados, especialmente ostras;
- Al exponer heridas abiertas al agua de mar donde están presentes las bacterias.
El riesgo de infección es mayor durante los meses cálidos, especialmente entre mayo y octubre, cuando la temperatura del agua supera los 20 °C (68 °F). Las aguas costeras y salobres son fuentes comunes de esta bacteria.
Algunas personas tienen más probabilidades de enfermarse gravemente si se infectan. Entre ellas se incluyen las personas con enfermedades del hígado, diabetes, cáncer, VIH u otras condiciones que debilitan el sistema inmunitario. Los hombres parecen tener un riesgo mayor que las mujeres, posiblemente debido al efecto protector del estrógeno.
Principales síntomas
Las infecciones por Vibrio vulnificus pueden causar diferentes síntomas, dependiendo de cómo la bacteria entra al organismo.
Si la infección proviene del consumo de alimentos contaminados, puede causar síntomas como:
- Diarrea;
- Dolor abdominal;
- Náusea;
- Vómito;
- Fiebre.
Cuando las bacterias entran a través de una herida, los síntomas pueden incluir:
- Enrojecimiento de la piel afectada;
- Hinchazón en la zona;
- Dolor;
- Ampollas con líquido en la piel.
La infección puede propagarse rápidamente y causar fascitis necrosante, una condición grave que destruye los tejidos blandos.
En casos severos, las bacterias pueden llegar al torrente sanguíneo y causar sepsis. Los signos de sepsis incluyen fiebre, escalofríos, presión arterial baja, confusión y lesiones en la piel. Este tipo de infección avanza con rapidez y puede ser potencialmente mortal si no se trata de forma inmediata.
Cómo se hace el diagnóstico
El diagnóstico de una infección por Vibrio vulnificus generalmente se realiza mediante el análisis de muestras de sangre, líquido de heridas o heces. Los métodos tradicionales de cultivo pueden detectar la bacteria, pero los resultados pueden tardar en obtenerse.
Métodos más recientes, como la PCR (reacción en cadena de la polimerasa) y la secuenciación metagenómica de nueva generación (mNGS), permiten identificar la bacteria de manera más rápida y precisa, especialmente cuando los cultivos dan resultados negativos. Se ha demostrado que la mNGS tiene una sensibilidad del 100 %, en comparación con solo el 39,1 % de los cultivos estándar.
También se están desarrollando algunas pruebas rápidas que utilizan tecnología CRISPR, las cuales podrían detectar Vibrio vulnificus en menos de una hora. Sin embargo, estos métodos aún no están ampliamente disponibles en los servicios clínicos.
Cómo se realiza el tratamiento
Es importante tratar las infecciones por Vibrio vulnificus lo antes posible a través del uso de antibióticos, que son la primera línea de defensa. Un tratamiento común incluye una combinación de doxiciclina y una cefalosporina de tercera generación, como ceftazidima. Asimismo, las fluoroquinolonas también pueden ser efectivas.
En casos de infección en heridas, puede ser necesario que los médicos eliminen el tejido dañado mediante cirugía. Esto es especialmente importante si la infección ha causado necrosis o se está propagando con rapidez. En algunas situaciones, la amputación puede ser la única opción para salvar la vida de la persona.
La atención hospitalaria puede incluir líquidos intravenosos, oxígeno y medicamentos para mantener la presión arterial. Las personas con síntomas graves o sepsis deben ser tratadas en unidades de cuidados intensivos, cuando sea posible.
Posibles complicaciones
Las infecciones por Vibrio vulnificus pueden avanzar muy rápido, especialmente en personas con enfermedades previas. Las infecciones del torrente sanguíneo, situación conocida como septicemia, causadas por esta bacteria tienen un alto riesgo de mortalidad, con tasas que varían entre el 33 % y más del 50 % en algunos estudios.
Las infecciones en heridas también pueden volverse graves. Si ocurre fascitis necrosante, el tejido afectado debe ser retirado quirúrgicamente. En algunos casos, la amputación es necesaria para evitar que la infección se propague.
Incluso con atención médica, las personas con el sistema inmunitario debilitado pueden no sobrevivir a la infección. La detección temprana y el tratamiento rápido son esenciales para reducir el riesgo de complicaciones graves o muerte.
Medidas de prevención
Existen varias formas de reducir el riesgo de infección por Vibrio vulnificus. Evitar el consumo de mariscos crudos o poco cocidos, especialmente ostras, es una de las medidas más importantes. Cocinar bien los mariscos elimina las bacterias.
Las personas con cortes o heridas abiertas deben evitar el contacto con agua de mar, especialmente en zonas costeras cálidas. Si el contacto es necesario, deben usarse vendajes impermeables o ropa protectora. Las heridas que hayan estado expuestas al agua de mar deben lavarse de inmediato con jabón y agua limpia.
Quienes padecen enfermedades del hígado, diabetes o tienen un sistema inmunitario debilitado deben ser especialmente cuidadosos durante los meses cálidos. Las autoridades de salud pública recomiendan revisar los avisos locales sobre el riesgo de Vibrio, especialmente después de huracanes o lluvias intensas, que pueden aumentar los niveles de bacterias en las aguas costeras.





























